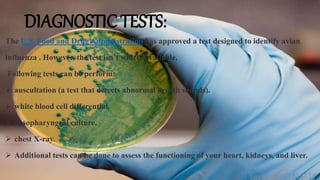
DIAGNOSTIC TESTS:
The U.S. Food and Drug Administration has approved a test designed to identify avian
influenza . However, the test isn’t widely available.
Following tests can be perform:
 auscultation (a test that detects abnormal breath sounds).
 white blood cell differential.
 nasopharyngeal culture.
 chest X-ray.
 Additional tests can be done to assess the functioning of your heart, kidneys, and liver.

The document discusses avian influenza (bird flu), caused by influenza A viruses that normally infect birds but can spread to humans. It describes the virus's history, subtypes including H5N1, diagnostic tests, treatment with antiviral medications, and prevention through avoiding contact with infected birds and practicing good hygiene. Risk factors include occupations working with poultry and traveling to affected areas. While usually mild in birds, some strains can cause serious illness in humans.